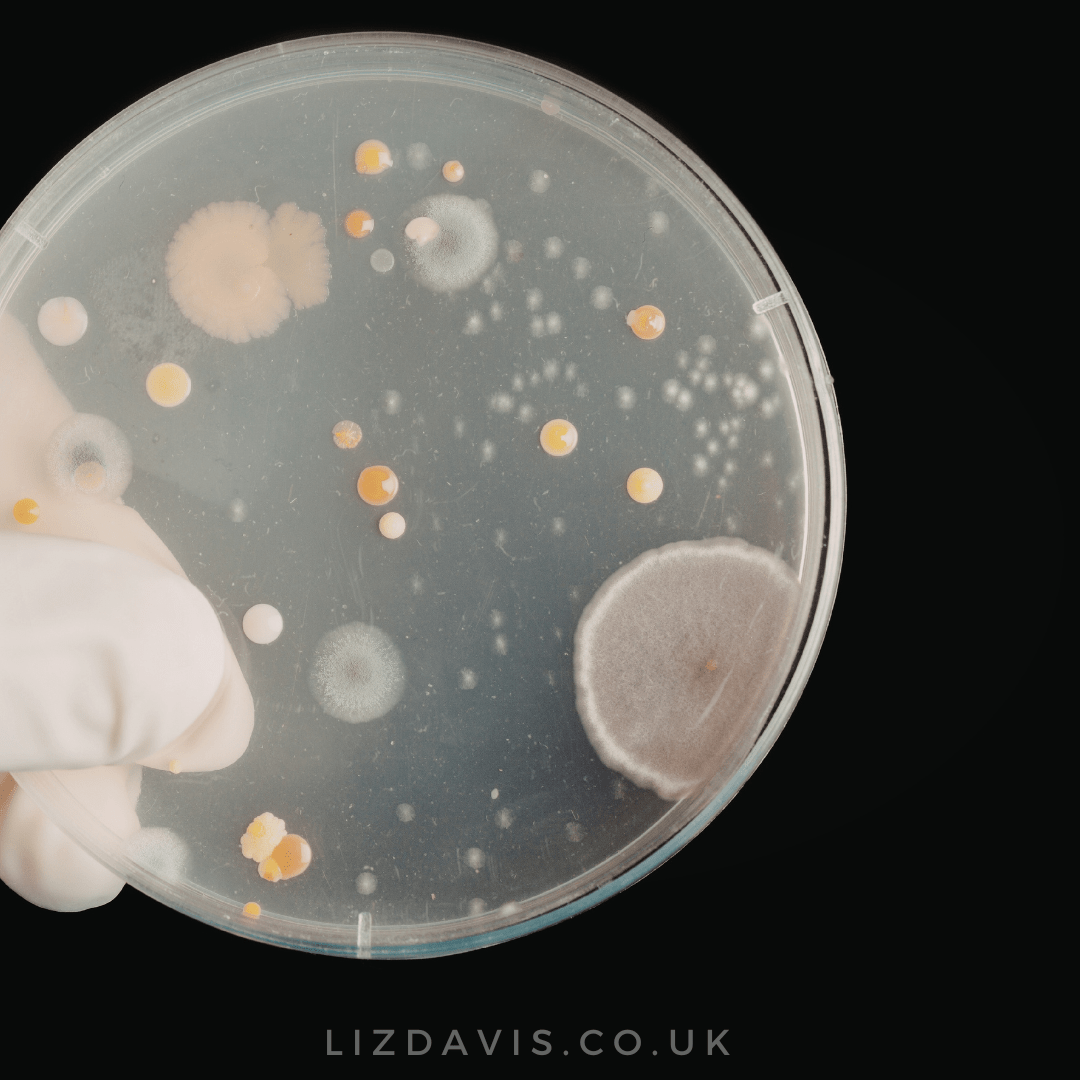

My Blog
What’s the Problem With Dairy? The Answer Might Surprise You
Dairy is one of the most common things people experiment with removing from their diet when...
Why a Healthy Diet Doesn’t Always Fix Gut Symptoms
A lot of people I speak to are already eating really well. They’ve cut out processed foods.They’re...
Caffeine and Gut Health: Could Tea & Coffee Be Triggering Your Symptoms?
Tea and coffee are such a normal part of everyday life that most people don’t think twice about...
Sugar Substitutes: Are They Making Your Gut Worse?
Sugar substitutes sound like the perfect solution, don’t they? A sweet taste without the calories,...
Postbiotics, Probiotics or Prebiotics?
Which is more important postbiotics, probiotics or prebiotics? By now most people have heard of...
Snacking & Gut Health: Why Grazing Could Be Sabotaging Your Digestion
Strangely enough, it’s often not what we’re eating that’s causing digestive trouble — it’s how...
Zinc & Gut Health: Are You Affected by a Hidden Deficiency?
(Hint: If you’ve got gut problems, you might be low in zinc.) Zinc is one of those quiet...
Yeast Overgrowth: Could Candida Be Running the Show in Your Gut?
“Having candida” is one of those phrases that gets thrown around a lot — often without much...
Low Iron Levels: Signs You’re Deficient (and How to Boost Absorption Naturally)
Low iron levels are far more common than most people realise — especially if you’re female and...
Insulin Resistance & Gut Health: What It Is, How It Starts, and Why Your Gut Is at the Centre
Insulin Resistance & Gut Health: What It Is, How It Starts, and Why Your Gut Is at the Centre...
IBS: Why One-Size-Fits-All Solutions Don’t Work (And What Actually Helps)
If you have IBS, you already know it’s frustrating, unpredictable, and disruptive to daily life....
Put Yourself First: Forget Challenges – Four Gentle Ways to Feel Better in 2026
It’s early January… and the internet is already shouting at us. Dry January. Veganuary. Sugar-free...
Free Mini Programme
Would You Like to Learn How to Fix Your Digestive Symptoms, Beat the Bloat and Feel Amazing?
1:1 Coaching Plans
Get Ready to Permanently Beat the Bloat, Soothe Your Digestion and Feel Amazing
Ultimate Gut Health Programme
Delicious, Filling & Inspiring ways to Become Symptom-Free, Soothe Your Gut and Enjoy Your Food Again!